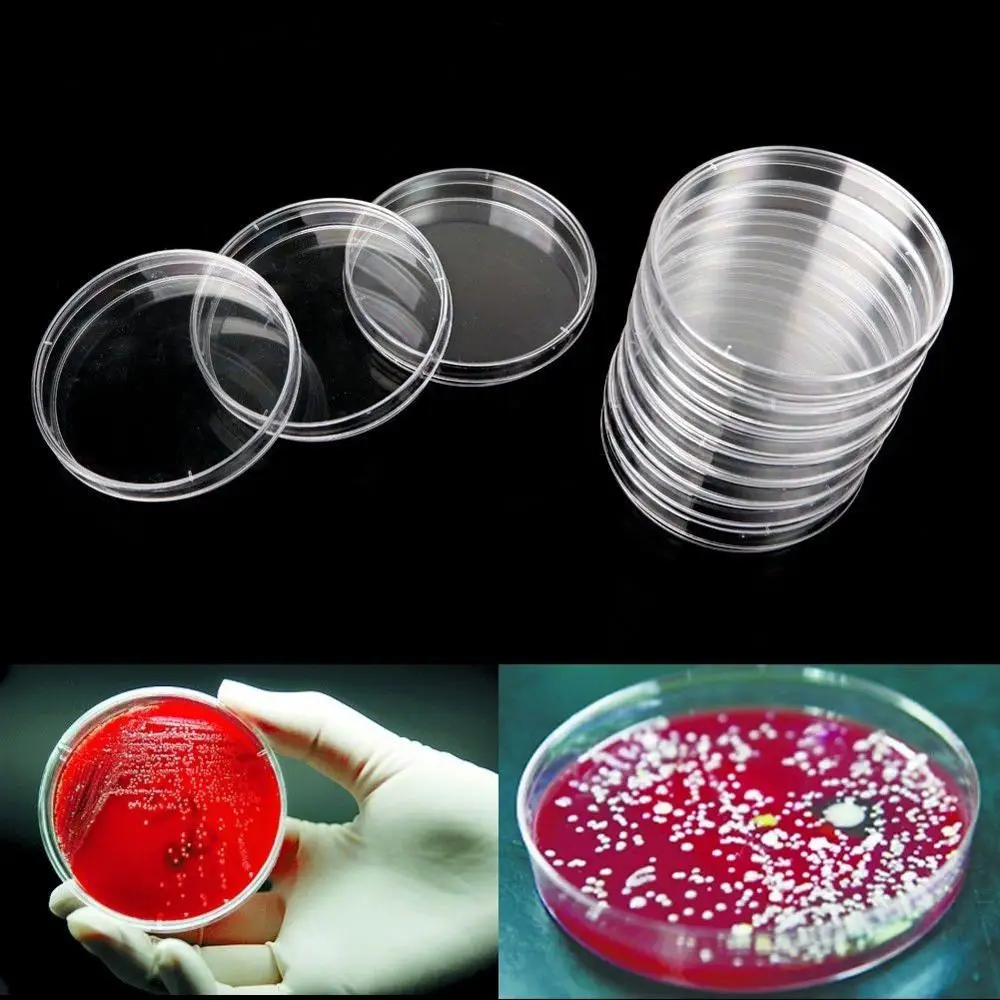
Petri Dish Filler

Petri Dish Filler
- Category: >>>
- Supplier: RECOMBIGEN LABORATORIES PRIVATE LIMITED
Share on (62011237032):
Product Overview
Description
Product Description
Specification
item | value |
Warranty | n/a |
Classification | Petri Dish |
Certification | ce |
Customized support | OEM |
Brand Name | Recombigen |
Model Number | TD730605-090 |
Place of Origin | India |
Delhi | |
Product name | Lab Disposable Plastic Petri Dish |
Usage | Lab Disposable |
working | Clinic/Hospital/Laboratories |
Material | Polystyrene Plastic |
Application | Lab Consumables |
Size | Standard Size |
Color | Transparent |
Packing | 500pcs/ Carton |
Packing & Delivery
Packaging & Delivery
Packaging Details
1000pcs/ctn (100pcs/pk, 10pk/ctn)
Delivery Time
5days after receive the deposit
Packaging Details
1000pcs/ctn (100pcs/pk, 10pk/ctn)
Delivery Time
5days after receive the deposit
Company Profile



Company Overview
Founded in New Delhi, India in the year 1999, Recombigen Laboratories Pvt. Ltd has earned the reputation of offering the best products for medical practitioners and re-invent the role of diagnostics in healthcare industry through prompt, reliable and convenient services. Being an ISO 9001:2008 certified company; the focus is to deliver quality oriented products at economical pricing and to make available the best in diagnostic industry in the Indian market. This vision has been achieved through alliances with leaders from across the globe, especially in France, Spain and USA for the procurement of the required products.
Recombigen has brought together various companies specializing in in-vitro diagnostic devices to establish an integrated and state of the art system, offering innovative solutions to advance clinical diagnostics in Indian laboratories. It manufactures and distributes products for clinical chemistry, rapid range microbiology, chemicals, reagents and laboratory stains and other laboratory plastic consumables and offers superior testing menu of liquid stables.
With a mission to improve patient care and enable better medical decisions, Recombigen has delivered high value diagnostic solutions to physicians/ Laboratories over the years. To ensure the quality and sustenance of the same, we have alliances from GMP compliant set ups with quality standards of 13485:2003 and CE marking.
Recombigen believes in direct sale of its products and has a distribution network of more than 2500 + dealers and distributors across the country. Additionally, Recombigen also provides several customized services to professional distributors and associated companies. Recombigen has been delivering OEM facility to various Big Brands for last 6 Years .Our highly advanced scientific procedures and extensive experience enables us to support branding and product customization effortlessly.
Recombigen has been operational since the year 1999 and has gained extensive experience of various components of the medical field over these 18 years.
In 1993 his Employer through his efforts procured raw materials from US to locally manufacture pregnancy test kits themselves but due to lack of financial viability, did not launch it commercially.
The year 1994-1995 witnessed expansion of the firm's business through viable partnerships with other organizations, to further accelerate the import of pregnancy test kits alongside other pharmaceutical products from China. The distribution of these products in the Indian market grew immensely.
The tactical break into the establishment of his own company came about in 1998 when the Promoters felt equipped to undertake more challenging roles and embark upon his much-awaited entrepreneurial journey. This is when he parted ways from his established employer, which led to the birth of Recombigen Laboratories Pvt. Ltd.
Recombigen was registered in 1999, with direct imports and sales of medical disposables, diagnostics, pharmaceuticals and rapid test kits. The milestone was achieved when the team decided to manufacture these products of supreme quality themselves in 2009. The Indian market had access to indigenously produced rapid test kits for pregnancy, ovulation, menopause, malaria, dengue and typhoid along with importation of other required products.
The company is now set to attain another landmark in the pharmaceutical market by setting up their own pan-India retail units to aid the process of distribution and enable easy access and all-time provision of superior healthcare to patients.
Founded in New Delhi, India in the year 1999, Recombigen Laboratories Pvt. Ltd has earned the reputation of offering the best products for medical practitioners and re-invent the role of diagnostics in healthcare industry through prompt, reliable and convenient services. Being an ISO 9001:2008 certified company; the focus is to deliver quality oriented products at economical pricing and to make available the best in diagnostic industry in the Indian market. This vision has been achieved through alliances with leaders from across the globe, especially in France, Spain and USA for the procurement of the required products.
Recombigen has brought together various companies specializing in in-vitro diagnostic devices to establish an integrated and state of the art system, offering innovative solutions to advance clinical diagnostics in Indian laboratories. It manufactures and distributes products for clinical chemistry, rapid range microbiology, chemicals, reagents and laboratory stains and other laboratory plastic consumables and offers superior testing menu of liquid stables.
With a mission to improve patient care and enable better medical decisions, Recombigen has delivered high value diagnostic solutions to physicians/ Laboratories over the years. To ensure the quality and sustenance of the same, we have alliances from GMP compliant set ups with quality standards of 13485:2003 and CE marking.
Recombigen believes in direct sale of its products and has a distribution network of more than 2500 + dealers and distributors across the country. Additionally, Recombigen also provides several customized services to professional distributors and associated companies. Recombigen has been delivering OEM facility to various Big Brands for last 6 Years .Our highly advanced scientific procedures and extensive experience enables us to support branding and product customization effortlessly.
Recombigen has been operational since the year 1999 and has gained extensive experience of various components of the medical field over these 18 years.
In 1993 his Employer through his efforts procured raw materials from US to locally manufacture pregnancy test kits themselves but due to lack of financial viability, did not launch it commercially.
The year 1994-1995 witnessed expansion of the firm's business through viable partnerships with other organizations, to further accelerate the import of pregnancy test kits alongside other pharmaceutical products from China. The distribution of these products in the Indian market grew immensely.
The tactical break into the establishment of his own company came about in 1998 when the Promoters felt equipped to undertake more challenging roles and embark upon his much-awaited entrepreneurial journey. This is when he parted ways from his established employer, which led to the birth of Recombigen Laboratories Pvt. Ltd.
Recombigen was registered in 1999, with direct imports and sales of medical disposables, diagnostics, pharmaceuticals and rapid test kits. The milestone was achieved when the team decided to manufacture these products of supreme quality themselves in 2009. The Indian market had access to indigenously produced rapid test kits for pregnancy, ovulation, menopause, malaria, dengue and typhoid along with importation of other required products.
The company is now set to attain another landmark in the pharmaceutical market by setting up their own pan-India retail units to aid the process of distribution and enable easy access and all-time provision of superior healthcare to patients.
FAQ
1. who are we?
We are based in India, start from 1999,sell to Domestic Market(25.00%),South Asia(10.00%),Northern Europe(10.00%),Central America(10.00%),North America(10.00%),Africa(10.00%),Southeast Asia(10.00%),South America(10.00%),Mid East(5.00%). There are total about 101-200 people in our office.
2. how can we guarantee quality?
Always a pre-production sample before mass production;
Always final Inspection before shipment;
3.what can you buy from us?
https://recombigen.com/product/preg-card-clear-sure/,https://recombigen.com/product/malaria-pf-pv-antigen/,https://recombigen.com/product/dengue-ns1-igg-igm-combo/,https://recombigen.com/product/syphilis-strip/,https://recombigen.com/product/s-typhi-igg-igm-card/
4. why should you buy from us not from other suppliers?
Recombigen Laboratories Pvt. Ltd has earned the reputation of offering the best products for medical practitioners and re-invent the role of diagnostics in healthcare industry through prompt, reliable and convenient services.
5. what services can we provide?
Accepted Delivery Terms: EXW;
Accepted Payment Currency:USD;
Accepted Payment Type: T/T,Credit Card,Cash;
Language Spoken:English,Hindi
We are based in India, start from 1999,sell to Domestic Market(25.00%),South Asia(10.00%),Northern Europe(10.00%),Central America(10.00%),North America(10.00%),Africa(10.00%),Southeast Asia(10.00%),South America(10.00%),Mid East(5.00%). There are total about 101-200 people in our office.
2. how can we guarantee quality?
Always a pre-production sample before mass production;
Always final Inspection before shipment;
3.what can you buy from us?
https://recombigen.com/product/preg-card-clear-sure/,https://recombigen.com/product/malaria-pf-pv-antigen/,https://recombigen.com/product/dengue-ns1-igg-igm-combo/,https://recombigen.com/product/syphilis-strip/,https://recombigen.com/product/s-typhi-igg-igm-card/
4. why should you buy from us not from other suppliers?
Recombigen Laboratories Pvt. Ltd has earned the reputation of offering the best products for medical practitioners and re-invent the role of diagnostics in healthcare industry through prompt, reliable and convenient services.
5. what services can we provide?
Accepted Delivery Terms: EXW;
Accepted Payment Currency:USD;
Accepted Payment Type: T/T,Credit Card,Cash;
Language Spoken:English,Hindi
We Recommend
New Arrivals
New products from manufacturers at wholesale prices